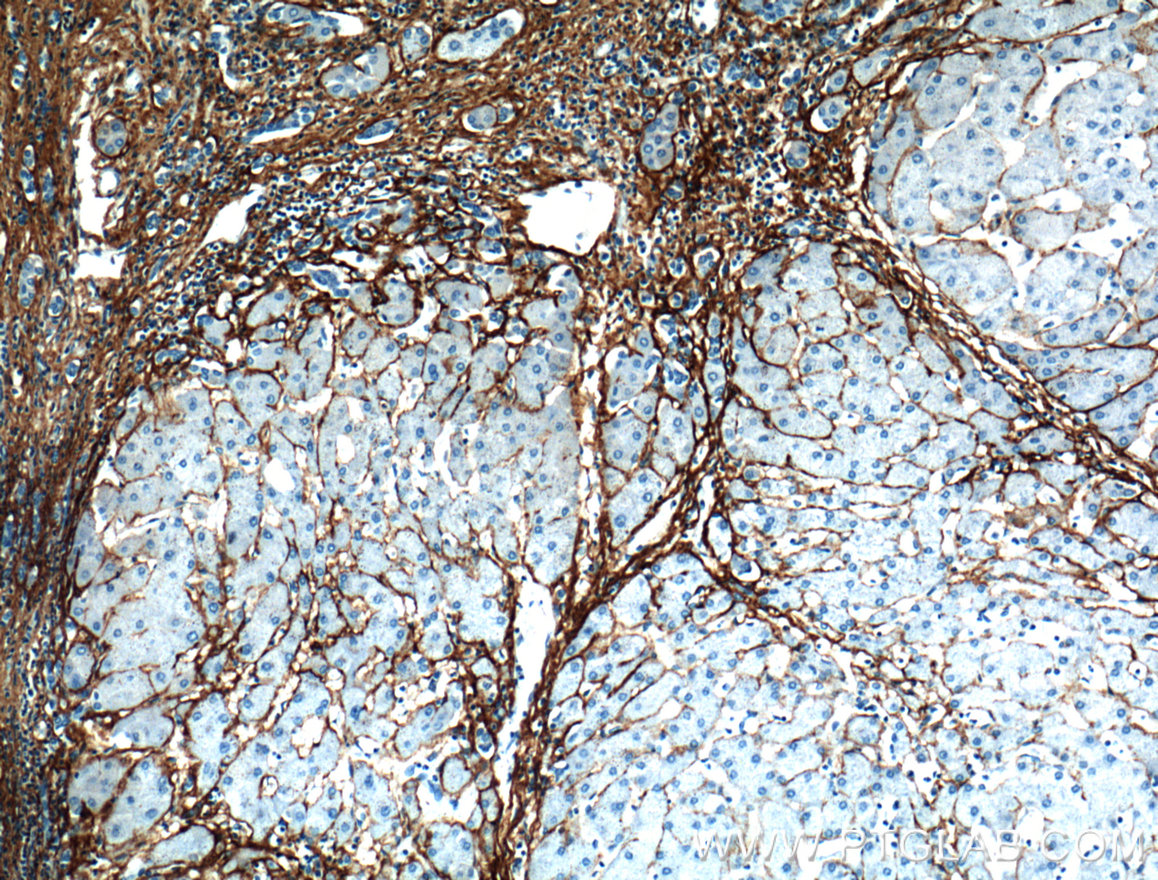
ihc staining of human hepatocirrhosis using 22734-1-ap
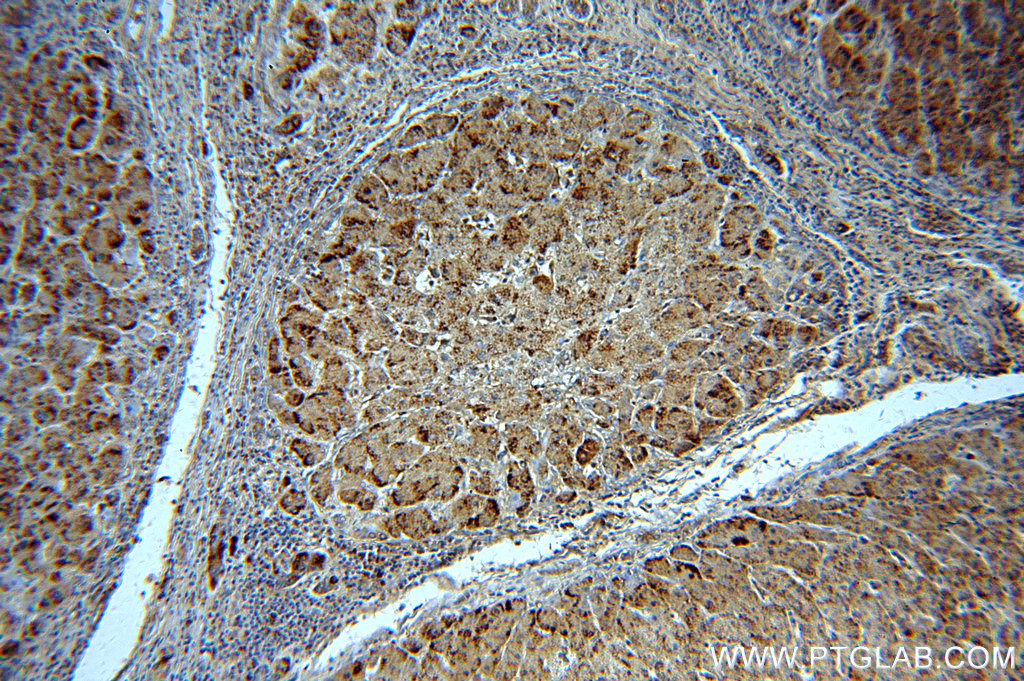
19792-1-ap;human hepatocirrhosis
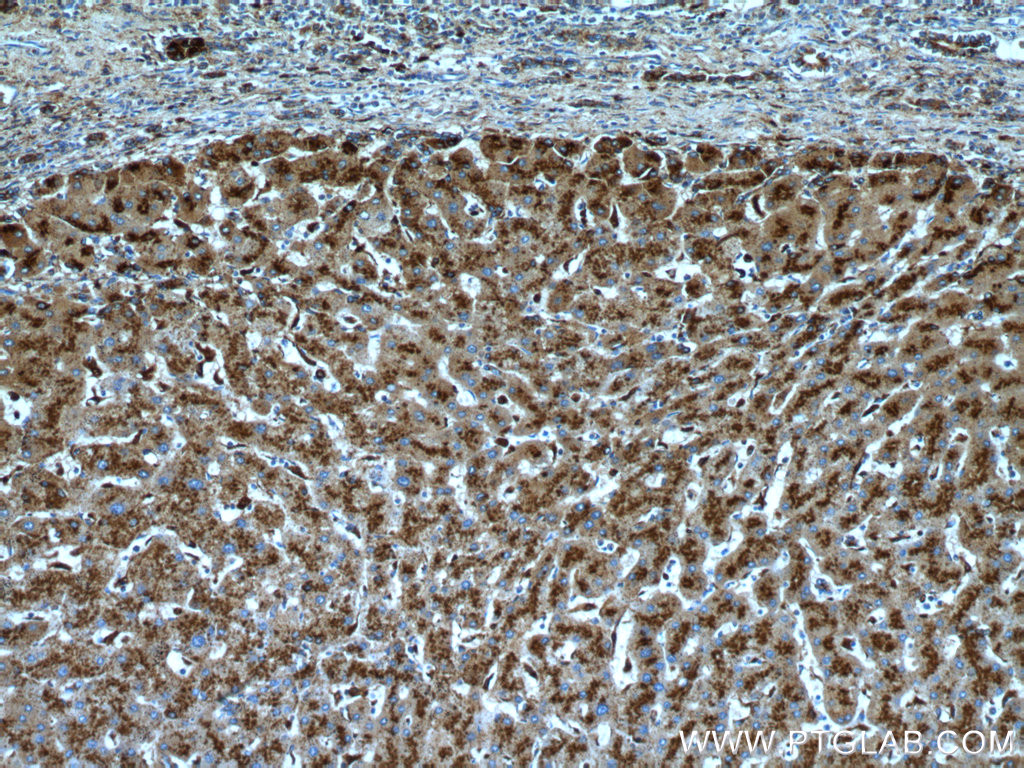
ihc staining of human hepatocirrhosis using 21327-1-ap
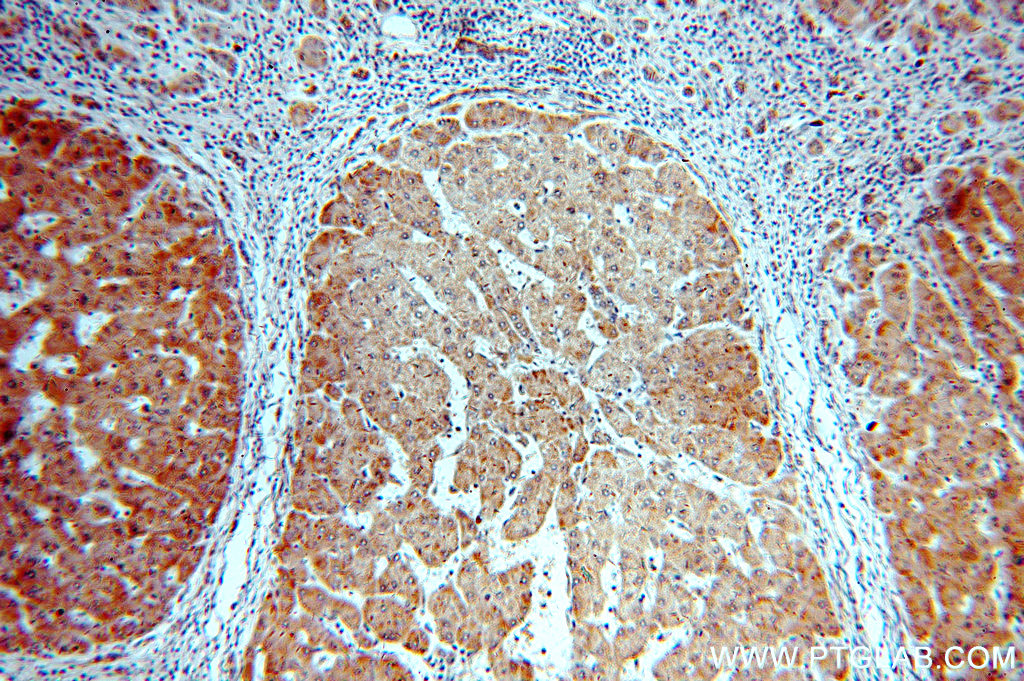
21555-1-ap;hepatocirrhosis
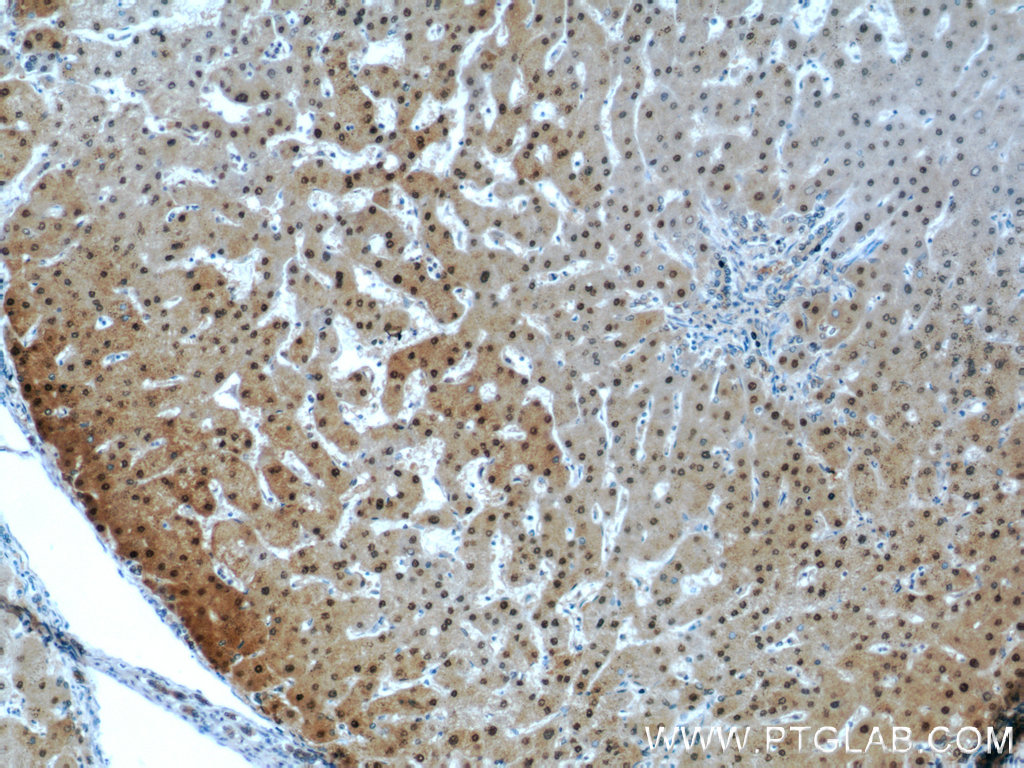
psmb5 antibody ihc human hepatocirrhosis tissue 19178-1-ap

hepatocirrhosis

ihc staining of human hepatocirrhosis using 22734-1-ap
图片尺寸1427x1085
临床药学培训---肝功能检验ppt
图片尺寸1080x810
ihc staining of human hepatocirrhosis using 19828-1-ap
图片尺寸1024x773
13621-1-ap;hepatocirrhosis
图片尺寸1024x681
ihc staining of human hepatocirrhosis using 22734-1-ap
图片尺寸1158x880
19792-1-ap;human hepatocirrhosis
图片尺寸1024x681
15285-1-ap;hepatocirrhosis
图片尺寸1024x681
20416-1-ap;human hepatocirrhosis
图片尺寸1024x681
19792-1-ap;human hepatocirrhosis
图片尺寸1024x681
20012-1-ap;hepatocirrhosis
图片尺寸1024x681
ihc staining of human hepatocirrhosis using 16314-1-ap
图片尺寸1024x681
ihc staining of human hepatocirrhosis using 17435-1-ap
图片尺寸340x258
19423-1-ap;hepatocirrhosis
图片尺寸1024x681
ihc staining of human hepatocirrhosis using 21327-1-ap
图片尺寸1024x768
19423-1-ap;hepatocirrhosis
图片尺寸1024x681
21260-1-ap;human hepatocirrhosis
图片尺寸1024x768
21555-1-ap;hepatocirrhosis
图片尺寸1024x681
20911-1-ap;hepatocirrhosis
图片尺寸1024x773
psmb5 antibody ihc human hepatocirrhosis tissue 19178-1-ap
图片尺寸1024x768
19563-1-ap;human hepatocirrhosis
图片尺寸1024x681